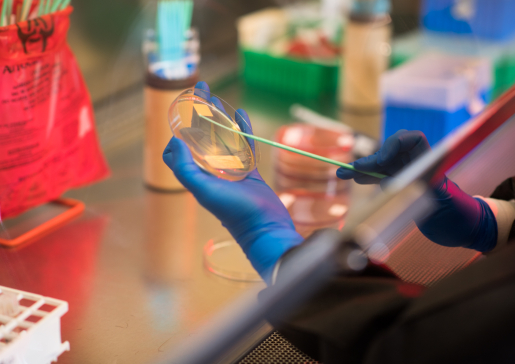
Closeup photo of researcher holding petri dish under lab hood

Reducing Healthcare-Associated Infections in Acute Care
Nasia Safdar, MD, Dr. Dennis G. Maki Endowed Faculty Fellow, is an internationally recognized leader on healthcare-associated infection (HAI) research, specifically C. difficile infection.
Her research employs methods from health systems engineering to comprehensively prevent and reduce HAIs, especially in the acute care setting.
Clinical Trials and Microbiome Research
Dr. Safdar's research team leads clinical trials and quality improvement projects to investigates interventions for HAIs, with a particular emphasis on reducing the burden of multi-drug resistant infections.
Her laboratory research focuses on the billions of microorganisms that live on and within the human body and that make up the microbiome. Her team is investigating the connection between the microbiome and infectious diseases across multiple body sites, mainly the skin, nose and gut.
Research Team

Lab Manager

Research Specialist

Research Health Scientist (VA)

Research Administrative Manager
Collaborator: Lindsay Kalan, PhD

There are many opportunities for motivated individuals in the Safdar Lab! We are currently seeking graduate students and postdocs interested in patient-oriented projects and clinical trials and/or microbiome and laboratory research.
If you are interested in joining the group, please send your CV and a brief description of your research experience and interests to Dr. Safdar.
Active Projects
- C. difficile and MDROs in the Healthcare Setting
We are evaluating novel therapeutics to treat HAIs and MDROs. For example, we are investigating probiotics and fecal microbiome transplants to treat recurrent C. difficile infections.
- Decolonization as a Prevention Strategy
HAIs are expensive and challenging to treat, which means novel methods of prevention are as important as effective and safe treatments. Because skin or gut colonization of MDROs can serve as a reservoir for subsequent infection, we are investigating novel decolonization measures. For example, we are interested in chlorhexidine gluconate bathing for methicillin-resistant Staphylococcus aureus (MRSA) decolonization and fecal microbiome transplants to eliminate Vancomycin-resistant Enterococci (VRE) carriage
- The Wisconsin Microbiome Study
This is a large, population-based cohort study across the state of Wisconsin that aims to understand the relationship between the nasal, gut, and skin microbiomes and colonization with multi-drug resistant organisms (MDROs).
A similar study in children is investigating the nasal, gut, and skin microbiomes of children between the ages of 6 months and five years. A major focus of this study is to assess the impact of daycare exposure on the microbiome and colonization with multi-drug resistant organisms (MRDOs).
- Veteran-Specific Studies
Projects specific to a veteran population are investigating the carriage of methicillin-resistant Staphylococcus aureus (MRSA) by analyzing nasal and gut microbiomes and seeking to understand Gulf War Illness through salivary and gut microbiomes.
Funding Support
Dr. Safdar's research is funded by the National Institutes of Health, the Agency for Healthcare Research and Quality, and the Veterans Health Administration.

